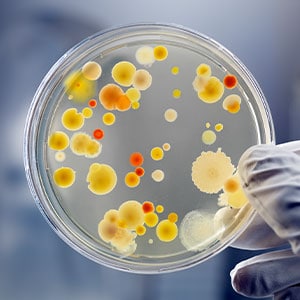

Viable Air Sampling
Introduction to Viable Air Sampling: Viable Environmental Monitoring Regulations related to viable air sampling play a pivotal role in shaping contamination control strategies in pharmaceutical manufacturing. The dynamic interplay of these regulations, both direct and indirect, is crucial for ensuring the safety and efficacy of drug products. With the advent of modern manufacturing concepts and the evolution of industry standards, the adoption of viable air monitoring becomes imperative to align with the latest regulatory trends.